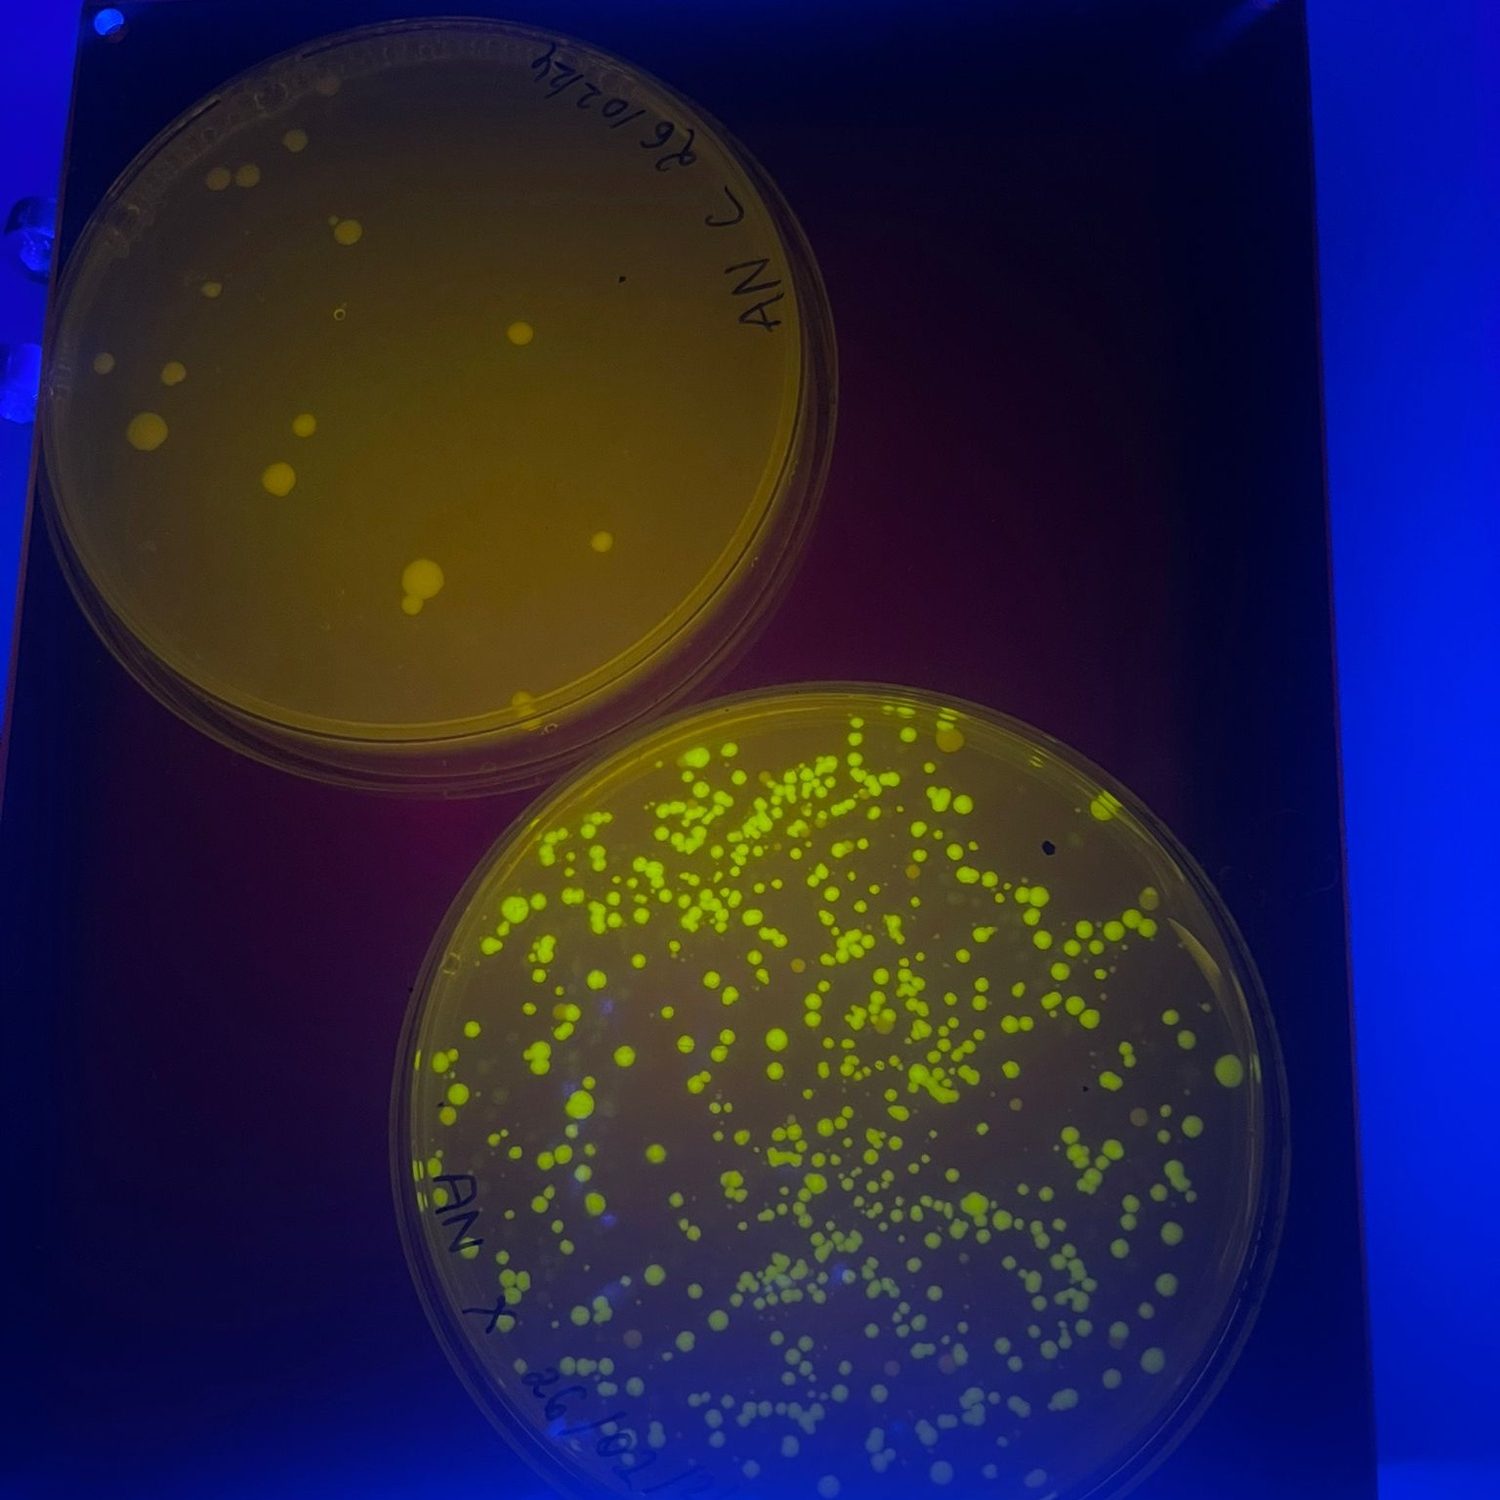
3f96a9eb-d397-4251-bb2b-93ff85bb5198-1

Key Skills:
Technical

Skilled in MATLAB, and data analysis, with experience in mechanical workshops (drilling, welding, milling, turning, laser cutting, 3D printing with Prusa and Bambu printers).
Engineering Expertise

Extensive experience in Finite Element Analysis (Marc Mentat, ANSYS), CAD (SolidWorks, Fusion 360), and SolidWorks CAM.
Laboratory
Proficient in wet-lab techniques, tissue engineering, and synthetic biology, applying CRISPR gene editing and metabolic pathway assembly in experimental work.
Hobbies:

- Fitness/Gym
- Bouldering
- Reading